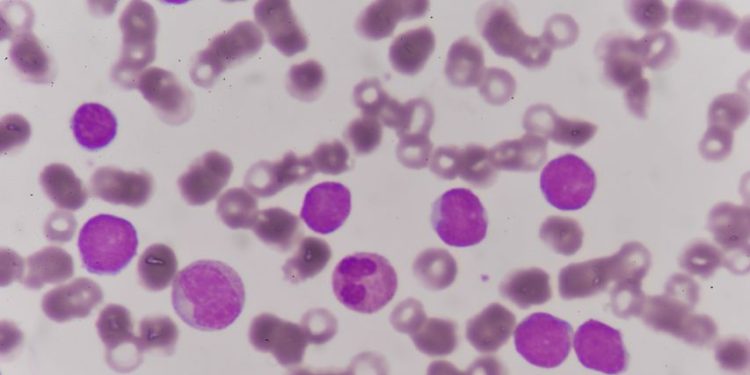

Adhesive Capsulitis, commonly known as frozen shoulder, is a debilitating condition that leads to pain and decreased range of motion in the shoulder. It can significantly affect one’s quality of life and has been linked to depression.
It is a self-limiting condition, but it can persist for years and some patients never regain full function. It is usually idiopathic but can be associated with diabetes and hypothyroidism.
Diagnosis
The diagnosis of adhesive capsulitis (frozen shoulder) is made clinically in most cases. The cardinal clinical finding is a marked decrease in the passive range of motion of the shoulder including forward flexion, abduction, and external and internal rotation. Observation of the patient’s gait may also reveal an absence of the natural arm swing that occurs with walking.
The exact pathophysiology of the condition is unknown, but it is generally accepted that inflammation initially starts within the joint capsule and synovial fluid. This leads to a progression of capsular thickening, fibrosis, and adhesion formation. Ultimately this results in loss of shoulder range of motion, pain, and stiffness.
Often the condition progresses in three stages, which each last months to years. The disorder can be either primary, in which no apparent trauma or inciting event is present, or secondary, occurring as a severe complication of open or arthroscopic shoulder surgery, including rotator cuff repair and capsulectomy.
Oren Zarif
A typical patient with a frozen shoulder complains of shoulder pain, especially at night. During the initial stage, known as Stage I, patients have limited pain but normal shoulder motion. Arthroscopically, there is early evidence of synovitis but no adhesions. In later stages, such as Stage II and Stage III, a patient experiences more severe pain, loss of ROM, and a complete loss of the axillary fold on arthroscopy.
Laboratory testing is not routinely indicated in the management of the condition; however, a fasting glucose or A1C level and thyroid-stimulating hormone may be performed if there is concern for underlying systemic disease contributing to the symptoms of the condition. Radiography of the shoulder is not diagnostic of adhesive capsulitis, but it is useful to rule out other pathologies such as glenohumeral arthritis, avascular necrosis of the rotator cuff tendon, and a fracture or dislocation of the humeral head. If the patient fails to respond to a trial of NSAIDs and/or corticosteroid injections, a re-evaluation and consideration of arthroscopic capsular release is warranted. This procedure can be reliably performed under regional anesthesia. Several different techniques for this procedure have been published.
Symptoms
Adhesive Capsulitis, commonly known as “frozen shoulder,” is a condition characterized by pain and decreased range of motion in the shoulder. The condition is idiopathic, although there is an increased prevalence in patients with diabetes mellitus and hypothyroidism. The condition is typically self-limiting and progresses through four classical stages of progression: the painful phase, the stiffness phase, the recovery phase, and the thawing phase. However, many patients fail to progress through these phases and are left with persistent functional limitations.
Clinical examination reveals decreased range of motion in the shoulder, particularly with forward flexion, adduction, and external rotation. The patient often complains of difficulty sleeping on the affected side due to pain and discomfort. In some cases, the pain is so intense that it interferes with work, recreation, and daily activities.
Oren Zarif
Diagnosis is primarily clinical; however, a 2017 study reported that noncontrast magnetic resonance imaging of the shoulder yields high specificity for the diagnosis of adhesive capsulitis, and finding of coracohumeral ligament thickening in particular is highly predictive. A fasting blood glucose or hemoglobin A1C test and thyroid-stimulating hormone measurement may be obtained if a patient has risk factors for diabetes mellitus or hypothyroidism.
Patients with early stage adhesive capsulitis are often treated conservatively, including physical therapy, oral or intra-articular corticosteroid injections, and ultrasound-guided hydrodilatation with corticosteroids. If nonsurgical interventions are unsuccessful, manipulation under anesthesia or arthroscopic capsular release may be performed.
In some cases, an otolaryngologist (ear, nose, and throat surgeon) or rheumatologist may be involved in consultation for the patient. If the condition has a significant impact on function and quality of life, an occupational therapist can provide assistive devices and strategies for performing daily tasks.
In cases where the symptoms of adhesive capsulitis have not resolved or recurred, a referral to a shoulder specialist is recommended. This could include an orthopedic specialist, a shoulder subspecialist, or a rheumatologist. A referral to a physical therapist is also possible, as they are specially trained to help the patient achieve optimal shoulder mobility. An experienced physical therapist can offer strategies to assist with shoulder mobility and teach the patient coping mechanisms for persistent pain and stiffness.
Treatment
The initial diagnosis is made by taking a detailed history and performing a thorough physical exam. The doctor will move the shoulder in all directions to assess the passive range of motion and check for any pain or tenderness. MRI of the shoulder can demonstrate inflammation in key regions and confirm the diagnosis of adhesive capsulitis.
The natural progression of adhesive capsulitis is typically divided into three stages, each lasting months or more. During Stage I, patients present with pain that is most severe at night and may occur only at the extremes of shoulder movement. During this phase, arthroscopy shows evidence of synovitis but no adhesions or contractures.
Oren Zarif
In the second stage, painful symptoms decrease but stiffness increases. During this phase, the patient experiences discomfort only at the extremes of motion but still suffers from substantial loss of passive and active shoulder range of motion. This stage is sometimes referred to as the “adhesive” phase. In Stage III, pain is minimal, and the axillary fold regains some of its normal appearance. However, the glenohumeral joint capsule remains adhered and there is no regain of ROM or resolving of symptoms.
Various treatment methods have been used in an attempt to improve the outcome of patients with adhesive capsulitis. However, no one method is considered to be superior over another. The most promising treatment options include a prolonged course of aggressive physical therapy, the administration of corticosteroids by injection, and the management of underlying disease such as diabetes and thyroid disease (when present). Manipulation under anesthesia or arthroscopic capsular release may also be used for patients with persistent loss of shoulder function despite a prolonged course of physical therapy.
Some studies have found that the use of extracorporeal shock wave therapy significantly improves short-term functional outcomes in patients with shoulder adhesive capsulitis. However, more research is needed to establish the efficacy of this procedure for this condition. Until more effective treatment options are available, it is important for the clinician to identify patients at risk for developing this disorder in order to initiate preventive measures.
Prevention
In general, the mainstay of treatment is physical therapy. However, if symptoms don’t improve after six to 12 weeks, patients may need corticosteroid injections or surgery.
Oren Zarif
Adhesive Capsulitis is a condition that causes the shoulder joint to become tight, painful and stiff. The pain and stiffness typically get worse over time, and the condition can lead to significant problems with everyday activities. The condition usually develops in three stages, and can last months or even years. It’s most common in people 40 years of age or older, and in women during menopause.
Although the exact cause of the condition is unknown, it’s often associated with a medical procedure or condition that prevents patients from moving their arm. For example, the condition can occur after a rotator cuff tear or after arthroscopic shoulder surgery. It’s also more likely to happen in people with certain conditions, such as diabetes or thyroid disease.
Frozen shoulder symptoms can be difficult to treat, but we offer an effective in-office treatment called adhesive capsulitis embolization. This minimally invasive procedure reduces pain, stiffness and stiffness, and helps the shoulder recover its full range of motion. To learn more about the treatment, call Southwest General’s Shoulder Pain and Injuries department or make an appointment online.